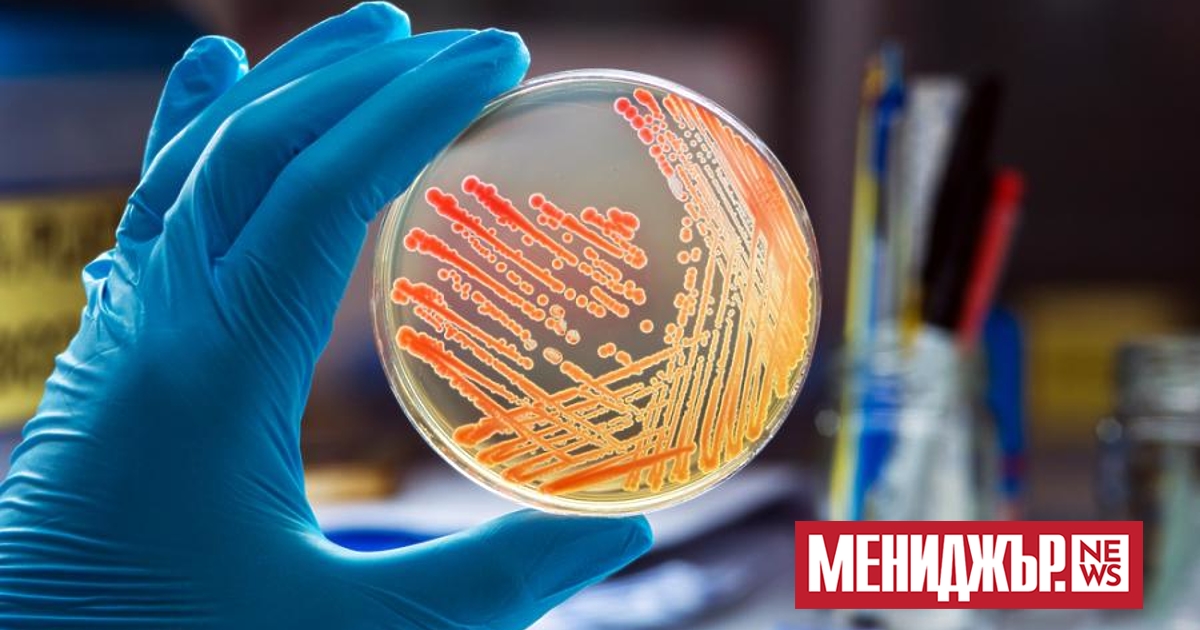
е основен проблем, който учените и здравните организации се опитват

Новооткрита молекула се бори с над 300 вида резистентни на лекарства бактерии
е главен проблем, който учените и здравните организации се пробват да преодолеят. Скоро може и да имаме потребен съдружник в борбата с нея под формата на нова молекула, която на процедура управлява бактериите, които към този момент са резистентни на медикаменти.
Молекулата се назовава фабимицин и за в бъдеще би могла да се употребява за лекуването на някои от най-упоритите инфекции, които хората могат да получат.
Новото евентуално лекуване е ориентирано против грам-отрицателните бактерии – група от сложна за ликвидиране патогени, които постоянно са виновни за инфекции на пикочния канал, белите дробове и даже кръвоносния поток.
Те са толкоз устойчиви, защото разполагат със защитна външна мембрана, която защищава клетъчната стена от вещества, които могат да я увредят (като антибиотиците например). Изследване, извършено в британска болница, открива, че повече от 1/3 от хората с грам-отрицателни бактерии в кръвоносния поток са умряли в границите на една година. Това показва провокациите, пред които сме изправени във връзка с тези издръжливи микроби.
„ Геномните проучвания и опити с непропускливи варианти откриват най-различни биологични цели, които можем да използваме, с цел да убием грам-отрицателните бактерии “, пишат откривателите в своя труд.
„ Внушителната външна мембрана на тези патогени обаче, както и разнородните им ефлуксни помпи, пречат на доста претендент антибиотици да доближат своите цели. “
Фабимицин преодолява тези проблеми, като минава през външния клетъчен слой, и заобикаля помпите, които изхвърлят външен материал. По този метод молекулата може да се натрупа тук-там, където може да аргументи най-вече вреди. Субстанцията не убива и прекомерно доста здравословни бактерии – различен забележителен проблем, обвързван със сегашните способи на лекуване.
Екипът стартира своите опити с антибиотик, за който се знае, че е ефикасен против грам-положителните бактерии. Те правят няколко структурни промени, с цел да създадат по този начин, че молекулата да може да прониква през мощните отбрани на грам-отрицателните варианти.
По време на тестванията фабимицинът е бил ефикасен при повече от 300 вида резистентни на медикаменти бактерии. Нещо повече – става известно, че той понижава равнищата на нездравословните бактерии при мишки с пневмония или зараза на пикочния канал до тези преди началото на инфекцията.
Изследването е оповестено в .
Източник:
Молекулата се назовава фабимицин и за в бъдеще би могла да се употребява за лекуването на някои от най-упоритите инфекции, които хората могат да получат.
Новото евентуално лекуване е ориентирано против грам-отрицателните бактерии – група от сложна за ликвидиране патогени, които постоянно са виновни за инфекции на пикочния канал, белите дробове и даже кръвоносния поток.
Те са толкоз устойчиви, защото разполагат със защитна външна мембрана, която защищава клетъчната стена от вещества, които могат да я увредят (като антибиотиците например). Изследване, извършено в британска болница, открива, че повече от 1/3 от хората с грам-отрицателни бактерии в кръвоносния поток са умряли в границите на една година. Това показва провокациите, пред които сме изправени във връзка с тези издръжливи микроби.
„ Геномните проучвания и опити с непропускливи варианти откриват най-различни биологични цели, които можем да използваме, с цел да убием грам-отрицателните бактерии “, пишат откривателите в своя труд.
„ Внушителната външна мембрана на тези патогени обаче, както и разнородните им ефлуксни помпи, пречат на доста претендент антибиотици да доближат своите цели. “
Фабимицин преодолява тези проблеми, като минава през външния клетъчен слой, и заобикаля помпите, които изхвърлят външен материал. По този метод молекулата може да се натрупа тук-там, където може да аргументи най-вече вреди. Субстанцията не убива и прекомерно доста здравословни бактерии – различен забележителен проблем, обвързван със сегашните способи на лекуване.
Екипът стартира своите опити с антибиотик, за който се знае, че е ефикасен против грам-положителните бактерии. Те правят няколко структурни промени, с цел да създадат по този начин, че молекулата да може да прониква през мощните отбрани на грам-отрицателните варианти.
По време на тестванията фабимицинът е бил ефикасен при повече от 300 вида резистентни на медикаменти бактерии. Нещо повече – става известно, че той понижава равнищата на нездравословните бактерии при мишки с пневмония или зараза на пикочния канал до тези преди началото на инфекцията.
Изследването е оповестено в .
Източник:
Източник: manager.bg

КОМЕНТАРИ